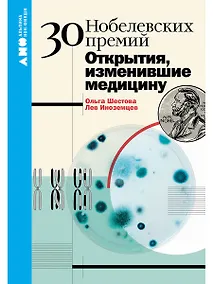
Купить 30 Нобелевских премий: Открытия, изменившие медицину — Фото №1

Королев Алексей Анатольевич: Гигиена питания. Руководство для врачей
Купили 20 раз
Купить в партнерских магазинах
О товаре
В руководстве изложены гигиенические основы питания человека, научно-практические аспекты теории рационального питания. Отражены современные данные о физиологических потребностях в пищевых веществах и энергии для различных категорий населения, приведены критерии пищевой и биологической ценности и безопасности основных групп продуктов, в том числе новых источников пищи. Рассмотрены в расширенном аспекте причины формирования и направления профилактики алиментарно-зависимых неинфекционных заболеваний и пищевых отравлений, механизмы алиментарной адаптации человека в условиях действия неблагоприятных факторов среды обитания.
Издание предназначено врачам различных специальностей, аспирантам, ординаторам, студентам медицинских вузов.
Характеристики
- Автор:
- Алексей Королев
- Издательство:
- ГЭОТАР-Медиа, ГЭОТАР-Медиа
- ISBN:
- Год издания:
- 2021
- Количество страниц:
- 576
- Переплет:
- Твёрдый переплёт
- Формат:
- 150x210 мм
- Вес:
- 0.74 кг
Похожие товары
Отзывов ещё нет — вы можете быть первым.
Дарим до 50 бонусов за отзыв